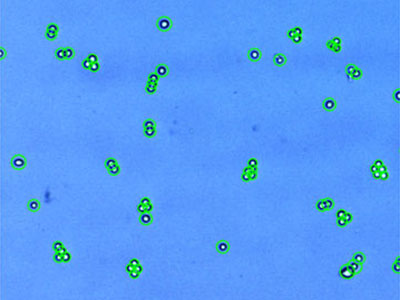
293-GFP： HEK293 stably expressing GFP
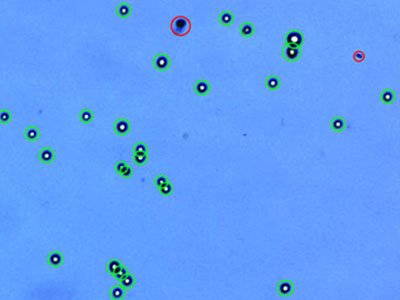
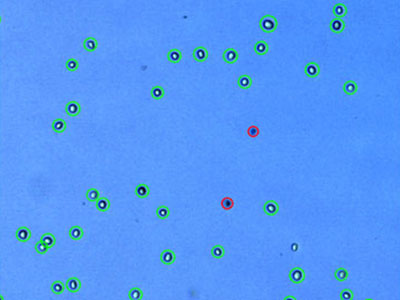
NIH3T3： Mouse embryonic fibroblast
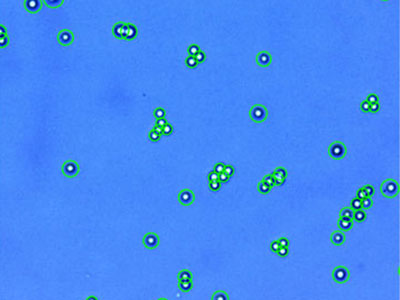
PANC-1： Human pancreatic ductal carcinoma
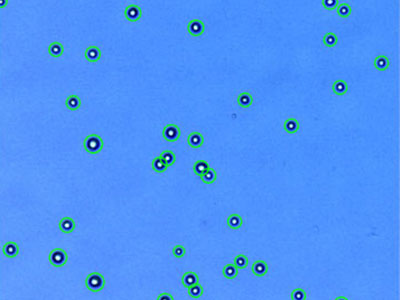
PC-3： Human prostate adenocarcinoma

Not Available in Your Country
Sorry, this page is not
available in your country.
Loading...
Overview
Accurate Cell Counting
- Accurately count clustered cells: The counter identifies single, clustered, live, and dead cells for counts with an accuracy similar to a hemocytometer.
- Exclude undesired particles with cell-size-based gates: Set the maximum and minimum cell sizes to filter for a given cell type.
- Accurately count small cells: The Live Cell Sensitivity function optimizes the recognition rate for cells less than 8 μm.
- Automated dilution calculator: Enter your desired concentrations, and the volume of cell suspension needed is automatically calculated.
- No trypan blue staining required: The Cell Counter can quickly count and present the total number of cells in a sample that has not been treated with trypan blue. The number of live cells can be estimated when the proportion of live/dead cells in the sample is known.
- Trypan blue concentration correction: The Auto Exposure Mode automatically corrects for variations in trypan blue concentration for stable count results.
|  |
|---|
 |
Clear Cell Images with Liquid Lens Autofocusing
The Cell Counter model R1 automatically focuses on cells using liquid lens technology, which works similar to how human eyes focus. The lens can autofocus in the Z-axis at the right position, producing more accurate and reproducible cell counting results. |
|---|
Efficient Cell Culture Data Management
Easy Data File Sharing
- Store up to 1,000 counts
- Easily export your data as a CSV file
- Result and image data can be stored as a TIFF, an annotated TIFF, or a PDF report file
- Easily transfer data using the cell counter’s USB ports
Comprehensive Report Results at a Glance
- No need to manually record detailed settings for each count
- Easily obtain report files containing the protocol used, the cell count results, the corresponding raw/analyzed cell images, and histograms
- Use review mode to view various reports on the touch screen at the same time, including the number of live/dead cells and average cell size
| 
|
|---|

|
Custom Cell Counting Parameters
Each detection parameter can be modified to fit the sample conditions. Up to 300 individual cell counting protocols can be saved and reloaded for use in routine procedures. |
|---|
User-Friendly Cell Counter Design
Portable with a Small Footprint
The handle on top of the counter makes it easy to transport, while its small footprint enables it to fit in tight spaces in your lab. A storage space in the back of the counter hides the AC adaptor and extension cord.
Convenient Touch Screen
The large touch screen at the base of the cell counter offers stability while making it simple to count cells, view data, and print the results.
Easy-to-Load Slides
It’s easy to add cells to the cell counter’s disposable slides through the loading slits. Two sets of cell counting are performed on one slide, making it easy to replicate runs. | 
|
Specifications
|
Cell Counting Time *1 |
Less than 10 s (manual focusing)
|
|---|
|
Less than 15 s (auto focusing)
|
|
Cell Concentration Range
|
5 × 104–1 × 107 cells/mL
|
|---|
|
Cell Diameter Range
|
3–60 μm (recommended: 8–30 μm)
|
|---|
|
Output Information *2 |
Total/live/dead cell concentration
|
|---|
|
Total/live/dead cell number
|
|
Viability
|
|
Average cell size
|
|
Image Resolution
|
5 megapixels, color
|
|---|
|
Focusing Mode
|
Automatic/manual focusing with liquid lens
|
|---|
|
Adjustable Parameters
|
Size, roundness, dilution factor, noise reduction, declustering
|
|---|
|
Image Type
|
TIFF, annotated TIFF
|
|---|
|
Report Format
|
PDF
|
|---|
|
Count Data Storage
|
1,000 counts
|
|---|
|
Protocol Storage
|
300 protocols
|
|---|
|
Display
|
LCD touchscreen: 800 × 480, 17.8 cm (7 in.)
|
|---|
|
USB Port
|
3 ports
|
|---|
|
Thermal Printer
|
Built in
|
|---|
|
Dimensions (W × D × H)
|
195 mm × 237 mm × 272 mm (7.7 in. × 9.3 in. × 10.7 in.)
|
|---|
|
Weight
|
2.1 kg (4.6 lb) (without the external power adaptor)
|
|---|
|
Input Power
|
AC 100–240 V, 50/60 Hz, 1.2 A
|
|---|
*1: Cell counting at less than 1 × 106 cells/ml concentration of HeLa or HL-60 cells.
*2: Live/dead cell concentration, number, and cell viability can be available with trypan blue mode. |
|
Material
|
Polystyrene
|
|---|
|
Dimensions (W × D × H)
|
75 mm × 25 mm × 2.3 mm (3 in. × 1 in. × 0.09 in.)
|
|---|
|
Chamber Volume
|
10 μL
|
|---|
|
Quantity Per Box
|
100 counts (50 slides, 2 chambers per slide)
|
|---|
Protocol Parameters
Name: Description
FF hiPS:Feeder-free Human iPS cells (201B7 cell line)
 | |
Protocol
|
Results
|
|---|
Noise reduction: 6
Roundness: 60%
Min. cell size (μm): 3
Max. cell size (μm): 60
Declustering level: Medium
|
Total cell conc. (cells/ml): 1.50 x 106
Live cell conc. (cells/ml): 1.38 x 106
Dead cell conc. (cells/ml): 1.19 x 105
Viability (%): 92.0
Average cell size (μm): 15.9
|
|
MEF:Murine embryonic Fibroblasts
 | |
Protocol
|
Results
|
|---|
Noise reduction: 7
Roundness: 60%
Min. cell size (μm): 3
Max. cell size (μm): 60
Declustering level: None
|
Total cell conc. (cells/ml): 1.03 x 106
Live cell conc. (cells/ml): 9.37 x 105
Dead cell conc. (cells/ml): 9.72 x 104
Viability (%): 90.6
Average cell size (μm): 19.6
|
|
A549: Human lung carcinoma
 | |
Protocol
|
Results
|
|---|
Noise reduction: 5
Roundness: 60%
Min. cell size (μm): 3
Max. cell size (μm): 60
Declustering level: Medium
|
Total cell conc. (cells/ml): 1.09 x 106
Live cell conc. (cells/ml): 1.07 x 106
Dead cell conc. (cells/ml): 1.78 x 104
Viability (%): 98.4
Average cell size (μm): 17.5
|
|
AsPC-1: Human pancreatic adenocarcinoma
 | |
Protocol
|
Results
|
|---|
Noise reduction: 5
Roundness: 60%
Min. cell size (μm): 3
Max. cell size (μm): 60
Declustering level: High
|
Total cell conc. (cells/ml): 7.51 x 105
Live cell conc. (cells/ml): 7.19 x 105
Dead cell conc. (cells/ml): 3.17 x 104
Viability (%): 95.8
Average cell size (μm): 10.7
|
|
C6: Rat glioma
 | |
Protocol
|
Results
|
|---|
Noise reduction: 5
Roundness: 60%
Min. cell size (μm): 3
Max. cell size (μm): 60
Declustering level: Medium
|
Total cell conc. (cells/ml): 1.31 x 106
Live cell conc. (cells/ml): 1.22 x 106
Dead cell conc. (cells/ml): 8.91 x 104
Viability (%): 93.2
Average cell size (μm): 12.1
|
|
Capan-2: Human pancreatic adenocarcinoma
 | |
Protocol
|
Results
|
|---|
Noise reduction: 5
Roundness: 60%
Min. cell size (μm): 3
Max. cell size (μm): 60
Declustering level: Medium
|
Total cell conc. (cells/ml): 1.04 x 106
Live cell conc. (cells/ml): 1.00 x 106
Dead cell conc. (cells/ml): 3.61 x 104
Viability (%): 96.5
Average cell size (μm): 13.4
|
|
DU 145: Human prostate carcinoma
 | |
Protocol
|
Results
|
|---|
Noise reduction: 5
Roundness: 60%
Min. cell size (μm): 3
Max. cell size (μm): 60
Declustering level: Medium
|
Total cell conc. (cells/ml): 1.86 x 106
Live cell conc. (cells/ml): 1.80 x 106
Dead cell conc. (cells/ml): 5.34 x 104
Viability (%): 97.1
Average cell size (μm): 14.3
|
|
293-GFP: HEK293 stably expressing GFP
| |
Protocol
|
Results
|
|---|
Noise reduction: 5
Roundness: 60%
Min. cell size (μm): 3
Max. cell size (μm): 60
Declustering level: Medium
|
Total cell conc. (cells/ml): 1.84 x 106
Live cell conc. (cells/ml): 1.82 x 106
Dead cell conc. (cells/ml): 2.23 x 104
Viability (%): 98.8
Average cell size (μm): 11.3
|
|
H1299: Human non-small cell lung carcinoma
 | |
Protocol
|
Results
|
|---|
Noise reduction: 5
Roundness: 60%
Min. cell size (μm): 3
Max. cell size (μm): 60
Declustering level: Medium
|
Total cell conc. (cells/ml): 4.14 x 105
Live cell conc. (cells/ml): 3.52 x 105
Dead cell conc. (cells/ml): 6.23 x 104
Viability (%): 84.9
Average cell size (μm): 19.5
|
|
H4: Human neuroglioma
 | |
Protocol
|
Results
|
|---|
Noise reduction: 5
Roundness: 60%
Min. cell size (μm): 3
Max. cell size (μm): 60
Declustering level: Medium
|
Total cell conc. (cells/ml): 2.08 x 105
Live cell conc. (cells/ml): 1.44 x 105
Dead cell conc. (cells/ml): 6.32 x 104
Viability (%): 69.6%
Average cell size (μm): 12.8
|
|
HCT116: Human colorectal carcinoma
 | |
Protocol
|
Results
|
|---|
Noise reduction: 5
Roundness: 60%
Min. cell size (μm): 3
Max. cell size (μm): 60
Declustering level: Medium
|
Total cell conc. (cells/ml): 1.34 x 106
Live cell conc. (cells/ml): 1.32 x 106
Dead cell conc. (cells/ml): 1.81 x 104
Viability (%): 98.7
Average cell size (μm): 12.2
|
|
HeLa: Human cervical carcinoma* | |
Protocol
|
Results
|
|---|
Noise reduction: 5
Roundness: 60%
Min. cell size (μm): 3
Max. cell size (μm): 60
Declustering level: Medium
|
Total cell conc. (cells/ml): 8.98 x 105
Live cell conc. (cells/ml): 8.11 x 105
Dead cell conc. (cells/ml): 8.69 x 104
Viability (%): 90.3
Average cell size (μm): 17.6
|
|
Hep3B: Human hepatocellular carcinoma
 | |
Protocol
|
Results
|
|---|
Noise reduction: 5
Roundness: 60%
Min. cell size (μm): 3
Max. cell size (μm): 60
Declustering level: Medium
|
Total cell conc. (cells/ml): 1.54 x 106
Live cell conc. (cells/ml): 1.49 x 106
Dead cell conc. (cells/ml): 5.87 x 104
Viability (%): 96.2
Average cell size (μm): 14.9
|
|
HL-60: Human acute promyelocytic leukemia
 | |
Protocol
|
Results
|
|---|
Noise reduction: 5
Roundness: 60%
Min. cell size (μm): 3
Max. cell size (μm): 60
Declustering level: Medium
|
Total cell conc. (cells/ml): 1.57 x 106
Live cell conc. (cells/ml): 1.45 x 106
Dead cell conc. (cells/ml): 1.23 x 105
Viability (%): 92.2
Average cell size (μm): 14.9
|
|
Hs 578T: Human mammary carcinoma
 | |
Protocol
|
Results
|
|---|
Noise reduction: 5
Roundness: 60%
Min. cell size (μm): 3
Max. cell size (μm): 60
Declustering level: Medium
|
Total cell conc. (cells/ml): 1.13 x 106
Live cell conc. (cells/ml): 8.72 x 105
Dead cell conc. (cells/ml): 2.62 x 105
Viability (%): 76.9
Average cell size (μm): 16.5
|
|
MCF7: Human breast adenocarcinoma
 | |
Protocol
|
Results
|
|---|
Noise reduction: 5
Roundness: 60%
Min. cell size (μm): 3
Max. cell size (μm): 60
Declustering level: Medium
|
Total cell conc. (cells/ml): 4.74 x 105
Live cell conc. (cells/ml): 4.43 x 105
Dead cell conc. (cells/ml): 4.07 x 104
Viability (%): 91.4
Average cell size (μm): 16.2
|
|
NIH3T3: Mouse embryonic fibroblast
| |
Protocol
|
Results
|
|---|
Noise reduction: 5
Roundness: 60%
Min. cell size (μm): 3
Max. cell size (μm): 60
Declustering level: Medium
|
Total cell conc. (cells/ml): 1.52 x 106
Live cell conc. (cells/ml): 1.33 x 106
Dead cell conc. (cells/ml): 1.96 x 105
Viability (%): 87.1
Average cell size (μm): 14.1
|
|
PANC-1: Human pancreatic ductal carcinoma
| |
Protocol
|
Results
|
|---|
Noise reduction: 5
Roundness: 60%
Min. cell size (μm): 3
Max. cell size (μm): 60
Declustering level: High
|
Total cell conc. (cells/ml): 1.23 x 106
Live cell conc. (cells/ml): 1.21 x 105
Dead cell conc. (cells/ml): 2.26 x 104
Viability (%): 98.2
Average cell size (μm): 15.3
|
|
PC-3: Human prostate adenocarcinoma
| |
Protocol
|
Results
|
|---|
Noise reduction: 5
Roundness: 60%
Min. cell size (μm): 3
Max. cell size (μm): 60
Declustering level: Medium
|
Total cell conc. (cells/ml): 1.36 x 106
Live cell conc. (cells/ml): 1.33 x 106
Dead cell conc. (cells/ml): 3.16 x 104
Viability (%): 97.7
Average cell size (μm): 17.2
|
|
STO: Mouse embryonic fibroblast
 | |
Protocol
|
Results
|
|---|
Noise reduction: 5
Roundness: 0%
Min. cell size (μm): 3
Max. cell size (μm): 60
Declustering level: Medium
|
Total cell conc. (cells/ml): 1.78 x 106
Live cell conc. (cells/ml): 1.50 x 106
Dead cell conc. (cells/ml): 2.81 x 105
Viability (%): 84.2
Average cell size (μm): 13.1
|
|
U-2 OS: Human osteosarcoma
 | |
Protocol
|
Results
|
|---|
Noise reduction: 5
Roundness: 60%
Min. cell size (μm): 3
Max. cell size (μm): 60
Declustering level: Medium
|
Total cell conc. (cells/ml): 7.66 x 105
Live cell conc. (cells/ml): 7.21 x 105
Dead cell conc. (cells/ml): 4.45 x 104
Viability (%): 94.2
Average cell size (μm): 16.0
|
|
U937: Human lymphoma
 | |
Protocol
|
Results
|
|---|
Noise reduction: 5
Roundness: 40%
Min. cell size (μm): 3
Max. cell size (μm): 60
Declustering level: Medium
|
Total cell conc. (cells/ml): 1.22 x 106
Live cell conc. (cells/ml): 1.12 x 106
Dead cell conc. (cells/ml): 1.02 x 105
Viability (%): 91.6
Average cell size (μm): 13.4
|
|
*Although it became one of the most important cell lines in medical research, it’s imperative that we recognize Henrietta Lacks’ contribution to science happened without her consent. This injustice, while leading to key discoveries in immunology, infectious disease, and cancer, also raised important conversations about privacy, ethics, and consent in medicine.
To learn more about the life of Henrietta Lacks and her contribution to modern medicine, click here. http://henriettalacksfoundation.org/
|